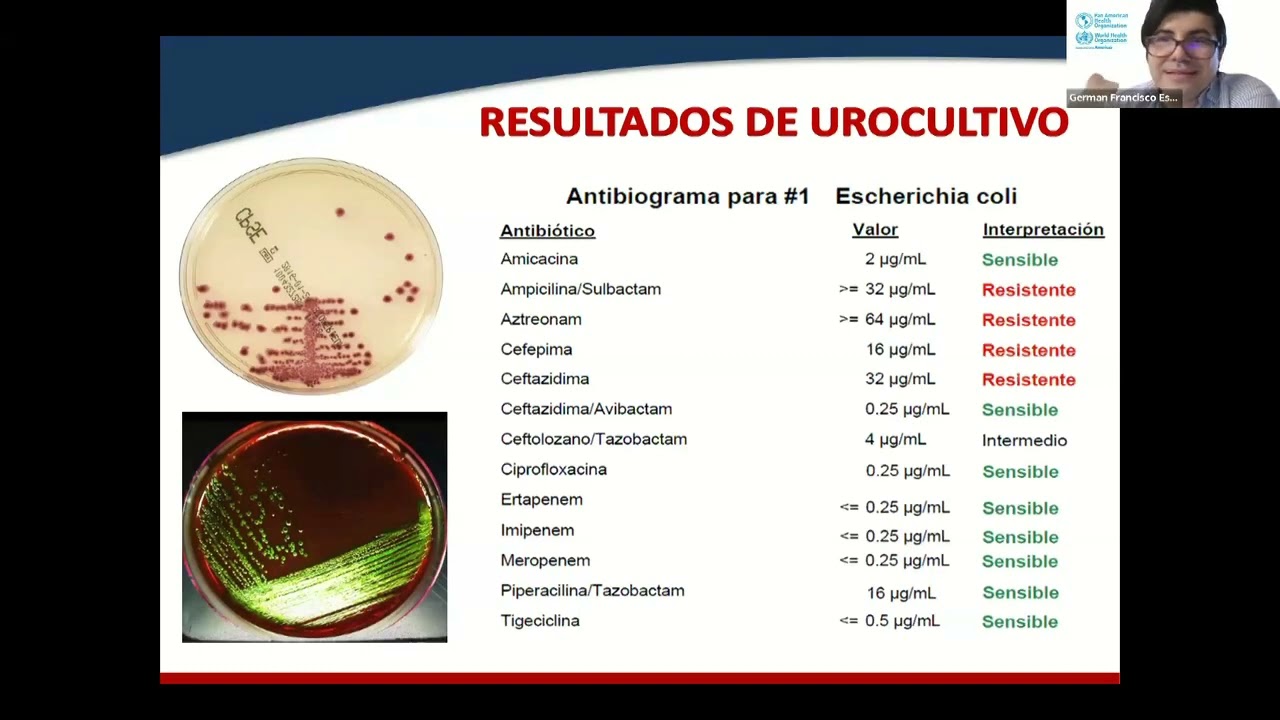
"Mecanismos de resistencia en bacterias Gram-negativas" Dr. Germán  Esparza

"Mecanismos de resistencia en bacterias Gram-negativas" Dr. Germán Esparza
Автор: MexY-PIDN
Загружено: 2024-01-27
Просмотров: 9921
"Mecanismos de resistencia en bacterias Gram-negativas" Dr. Germán Esparza
Доступные форматы для скачивания:
Скачать видео mp4
-
Информация по загрузке:



















